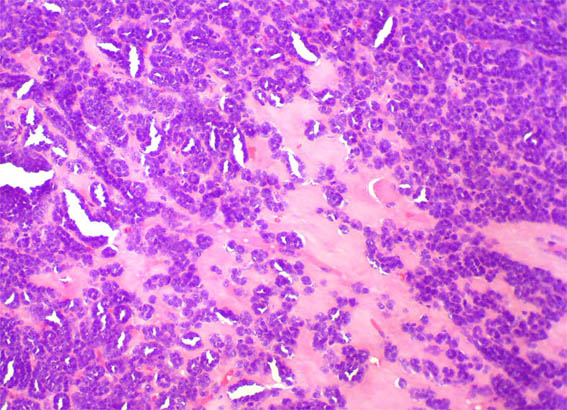

|
|
CASO
81 (Noviembre 2012)
Datos clínicos:
Hombre de 41 años de edad en quien
se encuentra, como hallazgo incidental, una masa de 4,2 x 4,0 x 4,0 cm
en el polo superior del riñón derecho. La masa se reseca
por nefrectomía parcial.
Nosotros recivimos en consulta cortes
histológicos del caso y no disponemos de imágenes macro.
Observe la histología:

Figura 1.
H&E, X100.

Figura 2.
H&E, X100.
Figura 3.
H&E, X200.

Figura 4.
H&E, X100.

Figura 5.
H&E, X200.

Figura 6.
H&E, X400.

Figura 7.
H&E, X200.

Figura 8.
H&E, X200.

Figura 9.
H&E, X200.

Figura 10.
H&E, X400.

Figura 11.
H&E, X200.

Figura 12.
H&E, X200.
¿Cuál es su diagnóstico?
Ver
diagnóstico y discusión
[Arriba]
|
|